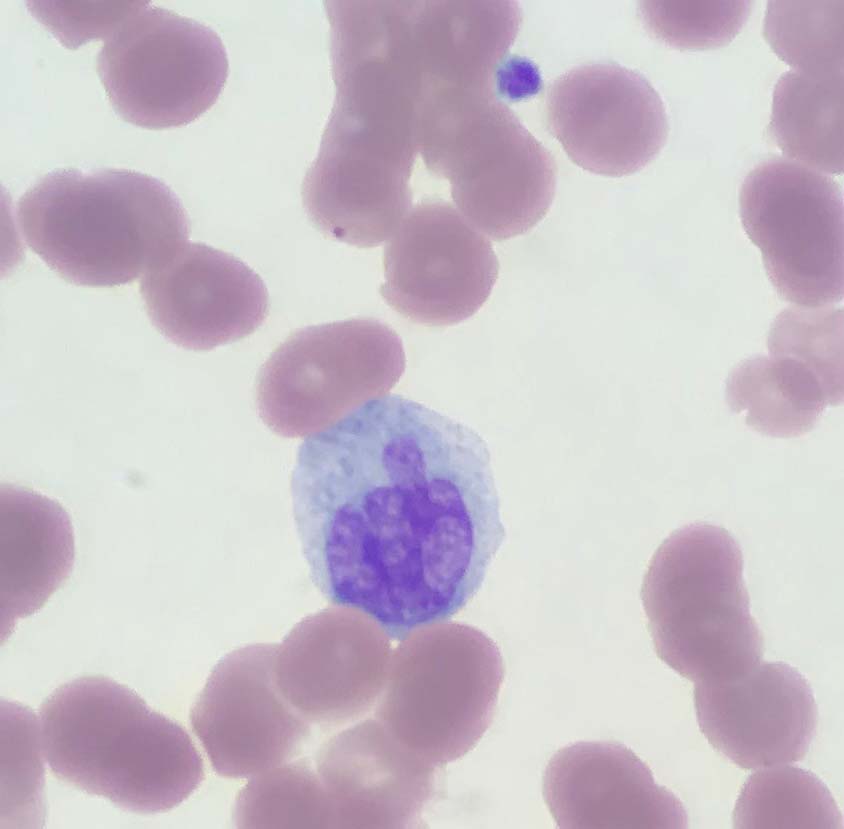
AmirBehdadMD's tweet image. Even monocytes have had enough with 2020! #hemepath

Vikram Raj
@drvikramraj
Genitourinary and Nephropathologist, Assistant Professor, Christian Medical College, Vellore
Tal vez te guste
#GodofWarRagnarok #GodofWar #Gameplay Need a recap of God of War 4 before release of Ragnarok? Visit my youtube channel for Gameplay walkthroughs Link for part 1 of walkthrough youtube.com/watch?v=jwO66A…

Excellent Venn diagram @rovingatuscap IDC-P vs HGPIN #GUpathJC
This is an excellent question - I like to use a Venn Diagram for this (see pic) #GUpathJC #ProstateCancer #gupath

The practice of pathology in the developed worlds vs Pathology here... Hilariously ridiculous!🤧😅🤣
Few take home messages on new Ag: 1)EXT1/EXT2: autoimmune dis, good prognosis, 2)NELL1: Mostly primary, 2nd common Ag, segmental staining, also malignancy asso- 3)Sema3B: childhood Ag, 4)PCDH7: older pts, non-complement activating, milder 5)NCAM1-primary & autoimmune dis 6) HTRA1

Paratesticular tumor. Unusual location but classic morphology for a glomus tumor! 😀😀 #gupath #pathology




Vimentin may be the most triggering IHC to order 😂 was surprised to see some of the other IHCs on this list, but Dr. Riddle did a great job explaining her reasoning 👍 @NRiddleMD @cap20virtual

Bladder, adult female @ZHOUSEH @MattieFarzin @rennmont @DrJPLow @ariella8 @RunjanChetty @JMGardnerMD @01sth02 @DrBMcGinn @s_prendeville @DrGeeONE @Dr_Brian_Cox @pembeoltulu @TheKarenPinto @kis_lorand @MarcosLepeMD #GUPath #Surgpath #pathtwitter




I just finished my guide to "Testicular Tumors" for my teaching website "Kurt's Notes" kurtsnotes.net Full handout here: schaberg.faculty.ucdavis.edu/wp-content/upl… #gupath #PathTwitter @SteveLongMD @MJMagersMD @Greg_Charville @kkuanMD @HubertLauMD @WKemp_MT_FPDoc




Impressive transition of benign prostatic epithelium (left) to flat HGPIN (right) #prostate #gupath #urology @UMichPath @PCF_Science #Medtwitter

Elegant work from @Tiff_Caza establishing NCAM1 as a novel autoantigen in membranous lupus nephritis @renalpathdoc @arkanalabs #sle #lupus @LupusResearch @LupusOrg @louise_oni kidney-international.org/article/S0085-…
Papillary cystadenoma of the rete testis. One of those things that you only see on the boards. I’ve seen maybe 1 in over a decade.
Let us finish the week with a beauty and a real rarity. A papillary cystadenoma of the rete testis. Somehow I feel I might persuade others, a WSI can make its way into the WHO 2021 testis blue book which I have the privilege of editing with @ro36693000 and Dr Satish Tickoo.

AJCC 8th edition regards it as lymph node involved by tumor

Tubulocystic RCC is the correct dx. 100% of the tumor need to exhibit his morphology. You should exclude FH deficient RCC before you make the dx. Watch this short video to see how this entity has evolved. Also don’t forget to subscribe to my channel. youtube.com/watch?v=Hgo99h…
youtube.com
YouTube
Tubulocystic Renal Cell Carcinoma
Check out @GU_Path_Society Q4 2020 Literature Watch curated by Drs. Rohit Mehra @drmehrarohit & Sounak Gupta @Shounak_Gupta - spanning the spectrum of #gupath & impact of COVID-19 on urologic medicine: gupathsociety.org/Literature-202… #GUPS #UroSoMe

FINAL DIAGNOSIS There are recently described and emerging entities that we need to know about. For this I am sharing two articles. 1- FINAL DIAGNOSIS - LOT: surgexppathol.biomedcentral.com/articles/10.11… 2 - Article for you to know emerging entities of Renal Neoplasia: surgexppathol.biomedcentral.com/articles/10.11… #uropath

A simple classic case, because if you need to know something for path and nephrology boards in renal path, you need to know about PLA2R positive membranous. It was a game changer. For patient care too. It all started here nejm.org/doi/full/10.10…



Older patient with AKI, asthma, and eosinophilia. Bx with pauci-immune necrotizing/crescentic GN. Eosinophils everywhere. Clinical diagnosis is EGPA. #renalpath




IgG4-related disease: all the findings! Fibrosing interstitial nephritis (storiform pattern), lymphoplasmacytic infiltrates with few eosinophils, plasma cells strongly positive for IgG4. There was a high IgG4:IgG ratio (not shown). Differential diagnosis includes ANCA-vasculitis.

United States Tendencias
- 1. #AEWDynamite 19.7K posts
- 2. Philon 1,478 posts
- 3. #AEWCollision 7,824 posts
- 4. #Survivor49 3,449 posts
- 5. #CMAawards 4,946 posts
- 6. Donovan Mitchell 3,790 posts
- 7. Dubon 3,475 posts
- 8. #cma2025 N/A
- 9. Derik Queen 2,477 posts
- 10. Simon Walker N/A
- 11. Nick Allen 2,056 posts
- 12. Bristow N/A
- 13. Naji Marshall N/A
- 14. Lainey Wilson N/A
- 15. UConn 7,972 posts
- 16. Josh Hart 2,277 posts
- 17. Okada 12K posts
- 18. Andrej Stojakovic N/A
- 19. FEMA 57.9K posts
- 20. Morgan Wallen 1,001 posts
Tal vez te guste
Something went wrong.
Something went wrong.